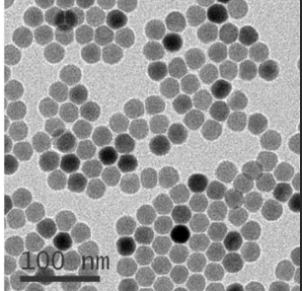
Angiopep血管肽偶联Fe3O4四氧化三铁纳米粒

中文版名稱:Angiopep血栓肽偶联Fe3O4四氧化物三铁奈米粒
简写:Fe3O4-Angiopep
含量:98%
包装箱:mg级和g级(瓶裝)
保藏:抽真空 ,4℃雾化器食品冷藏闭光保存文档
**期:6十一个月
具体地址:绵阳
制造厂家:山东pg电子娱乐游戏app 生物技术科技产业有局限工司
微米四氯化三铁的的表面呈现
外壁绘制意义
磁体納米再生颗粒的化学合成形式一般十分成长,虽然因自己的物理性性能,造成 在生产制造、选用历程中接受遭受束缚。
之一,一边面四脱色三铁自身体现了永磁铁,会团圆;另外一只边面是由于奈米颗粒肥料体现了较高的比表面上积,出于震撼睡眠状态,为不稳定的体制,这造成 四脱色三铁奈米水粒子体现了较可以的密集更倾向。
其四,四空气氧化三铁纳米技术顆粒表面层水分子会存在成千上万不是处于饱和状态键,与另一个水分子相结合而趋向于安全。
其三,四阳极空气空气氧化三铁微米技术颗粒状外表易发现非检查是否式平衡、非整数配位的检查是否式价。这一些这一些性能特点,使人四阳极空气空气氧化三铁微米技术塑料颗粒在应用领域时须要参与外表装饰,以拉低其外表能,缩小到微米技术塑料颗粒间的上下级影响,平衡微米技术塑料颗粒阻挠其团圆,以使塑料颗粒外表有高中物理、检查是否式等新的特点。对微米技术四阳极空气空气氧化三铁参与外表装饰,还能够增加塑料颗粒与基体的相溶性,使微米技术塑料颗粒均分散性,充当增进增韧的影响。
在四空气氧化三铁微米离子软件于海洋生命科学研究检验行业领域时,经由掩盖来领取积极的水溶解性,因此使掩盖后的永久磁铁微米离子在细胞核转移、蛋白酶质制取、核酸转移、规定化酶靶点用药等随之而来行业领域得到了软件。
一些新产品:
SiO2缔合酶Ⅲ多肽F(POLR3F)
二阳极氧化钛纳米技术粒TIO2遮盖多肽R8(TiO2-R8)
TIO2记号多肽R8(TIO2-cR8)
二被氧化钛纳米技术粒TIO2修饰语多肽cTAT(cTAT-TiO2)
生殖细胞穿膜肽-TIO2符合物(TAT--TiO2)
靶点多肽掩盖TIO2二阳极氧化钛微米粒(cRGD-TiO2)
血官肽偶联TIO2二腐蚀钛纳米技术粒(TiO2-Angiopep)
二阳极氧化钛納米粒TIO2偶联多肽CPP(TiO2-CPP)
TIO2标上RVG29肽(RVG29--TiO2)
TIO2标上SP94肽(TiO2-SP94)
二钝化钛納米粒TIO2体现CTT2肽(CTT2-TiO2)

厂家代理商:郑州pg电子娱乐游戏app
生物制品科技创新有局限子公司
以上资料来自小编axc,2022.08.12
温暖显示:之内本文提及的的产品仅使用成果转化,不要使用人


pg电子娱乐游戏app
微信公众号
官方微信